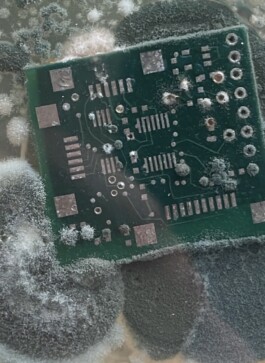
Julie C. Stamm
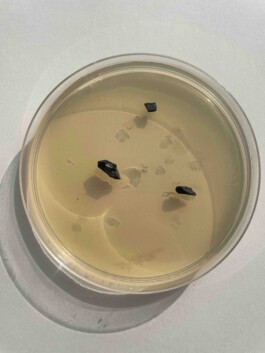
Julie C. Stamm

Never Lick Your Phone, Again is a living installation of microorganisms cultivated from contact with everyday technologies as well as from obsolete electronics. Bacterial cultures—collected through human interaction with devices and directly from electronic waste—are grown and observed within the controlled environment of the exhibition space, unfolding over time.

Between decay and growth, the work foregrounds traces, residues, and accumulations as central protagonists. What usually remains invisible—microbial life, material leftovers, the afterlives of interaction—becomes aesthetic surface and temporal process. The installation brings together biological activity and technological materiality, allowing them to intersect, contaminate, and transform one another.

At its core, the work engages with the tension between the promise of technological preservation and the reality of continuous transformation. While digital culture is shaped by narratives of permanence and endless accessibility, its material substrates degrade, become obsolete, and slip into unreadability. The cultivated microorganisms mark an early, living stage of these processes, while obsolete hardware points to their later phases.


After use: discard.

Never Lick Your Phone, Again is a living installation of microorganisms cultivated from contact with everyday technologies as well as from obsolete electronics. Bacterial cultures—collected through human interaction with devices and directly from electronic waste—are grown and observed within the controlled environment of the exhibition space, unfolding over time.

Between decay and growth, the work foregrounds traces, residues, and accumulations as central protagonists. What usually remains invisible—microbial life, material leftovers, the afterlives of interaction—becomes aesthetic surface and temporal process. The installation brings together biological activity and technological materiality, allowing them to intersect, contaminate, and transform one another.

At its core, the work engages with the tension between the promise of technological preservation and the reality of continuous transformation. While digital culture is shaped by narratives of permanence and endless accessibility, its material substrates degrade, become obsolete, and slip into unreadability. The cultivated microorganisms mark an early, living stage of these processes, while obsolete hardware points to their later phases.

After use: discard.
© 2025 Julie C. Stamm